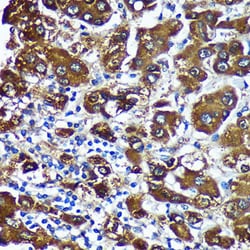
Invitrogen CTNNA3 Polyclonal Antibody 100 &mu;L | Buy Online | Invitrogen&trade; | Fisher Scientific

Learn More
Invitrogen™ CTNNA3 Polyclonal Antibody


Description
Positive test controls include: LO2, 293T, Mouse spleen, Rat brain. The target is usually found in the following locations: Cytoplasm, cytoskeleton. Immunogen sequence: MKSTQRREKQ GSMSAETPIT LNIDPQDLQV QTFTVEKLLE PLIIQVTTLV NCPQNPSSRK KGRSKRASVL LASVEEATWN LLDKGEKIAQ EATVLKDELT ASLEEVRKES EALKVSAERF TDDPCFLPKR EAVVQAARAL LAAVTRLLIL ADMIDVMCLL QHVSAFQRTF ESLKNVANKS DLQKTYQKLG KELENLDYLA FKRQQDLKSP NQRDEIAGAR ASLKENSPLL HSICSACLEH.

Specifications
Specifications
| Antigen | CTNNA3 |
| Applications | ELISA, Immunohistochemistry (Paraffin), Western Blot, Immunocytochemistry |
| Classification | Polyclonal |
| Concentration | 1.58 mg/mL |
| Conjugate | Unconjugated |
| Formulation | PBS with 50% glycerol and 0.01% thimerosal; pH 7.3 |
| Gene | CTNNA3 |
| Gene Accession No. | Q65CL1, Q9UI47 |
| Gene Alias | 4930429L08Rik; 4933408A16; Alpha T-catenin; Alpha-3 catenin; alpha-catenin-like protein; alpha-T-catenin; ARVD13; Cadherin-associated protein; catenin (cadherin associated protein), alpha 3; catenin (cadherin-associated protein), alpha 3; catenin alpha 3; catenin alpha-3; Catna3; CTNNA3; RGD1559455; RGD1562230; Vr22 |
| Gene Symbols | CTNNA3 |
| Show More |
By clicking Submit, you acknowledge that you may be contacted by Fisher Scientific in regards to the feedback you have provided in this form. We will not share your information for any other purposes. All contact information provided shall also be maintained in accordance with our Privacy Policy.